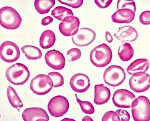
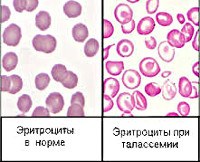

Киберис понимает введённое. Например, управляющие команды:
- Открытие страниц («покажи», «читать», «открой» + страница и т.д.)
- Добавление препаратов в сервисы («проверь», «совместимость», «сравни», «аналог» + препарат и т.д.)
- Работа в подборе лечения («добавь», «назначь», «удали назначение», «расшифруй» + симптом и т.д.)
- Заполнение и поиск в бланках («какой уровень», «это норма?», «расшифруй» + значение и т.д.)
|